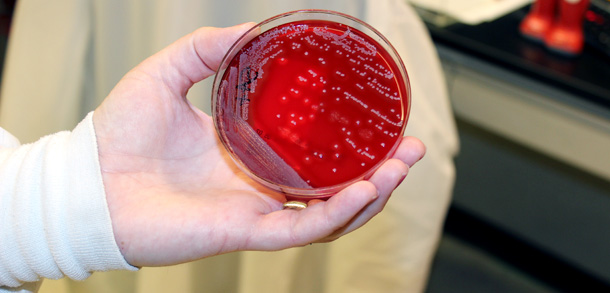
анализы

Стафилококк относится к категории условно-патогенных бактерий, которые в минимальной концентрации присутствуют на покровах кожи любого человека. Когда для этих микроорганизмов создается благоприятная среда, они активизируются и начинают размножаться. Стафилококковая инфекция чаще всего поражает слизистые носоглотки, а также проникает в дыхательные пути и другие органы. На фоне массового обсеменения у людей развиваются воспалительные процессы в легких, и более тяжелые осложнения.
Что такое и как выглядит золотой стафилококк

Изучая стафилококк под микроскопом можно увидеть шарообразную бактерию, имеющую правильную форму. Она относится к категории неподвижных грамположительных кокков, насчитывающей 27-мь видов микробов. Стоит отметить, что несмотря на такое количество разновидностей стрептококковых микроорганизмов, только три типа являются условно-патогенными и провоцируют развитие заболеваний.
Прогрессируя в человеческом организме, патогенные микроорганизмы начинают активно размножаться, в результате чего образуют целые колонии, по форме напоминающие виноградные грозди. Этот условно-патогенный микроб обладает максимально высокой устойчивостью к антибактериальным лекарственным средствам, поэтому на сегодняшний день патологии стафилококковой природы занимают лидирующие позиции среди всего списка воспалительно-гнойных заболеваний.
Золотистый стафилококк является одним из наиболее распространенных патогенов, вызывающих инфекции у взрослых. Врачи отмечают, что основными причинами заражения являются несоблюдение правил личной гигиены, травмы кожи и ослабленный иммунитет. Симптомы инфекции могут варьироваться от легких кожных высыпаний до серьезных заболеваний, таких как пневмония или сепсис. Важно обращать внимание на такие проявления, как покраснение, отек и гнойные выделения. Лечение обычно включает антибиотики, однако устойчивость некоторых штаммов к медикаментам требует индивидуального подхода. Врачи подчеркивают важность своевременной диагностики и профилактики, чтобы избежать серьезных осложнений.
https://youtube.com/watch?v=ARu6i7bxOWY
Что убивает золотистый стафилококк

Этот условно-патогенный микроорганизм не боится медикаментов, обладающих антибактериальными свойствами. Он способен на протяжении длительного временного промежутка сохранять жизнеспособность, находясь в высушенном состоянии. Также бактерия хорошо переносит воздействие высокими температурными режимами и погибает только при повышении показателя градусника выше 70-ти градусов. Чтобы избавиться от золотистого стафилококка необходимо его в течение получаса держать при температуре, варьирующейся в диапазоне от 20-ти до 30-ти минут. Мгновенно уничтожить условно-патогенный микроорганизм можно поместив его в среду, температура которой составляет 150-т градусов.
Классификация
На сегодняшний день ученым удалось классифицировать следующие виды стафилококка, входящие в группу условно-патогенных микроорганизмов:
- Сапрофитный.
- Эпидермальный.
- Золотистый.
Самым опасным из этих трех типов условно-патогенных грамположительных микробов является последний вид. Проявляется золотистый стафилококк у людей разных полов и возрастных групп характерной симптоматикой, но также может иметь бессимптомное течение. Согласно статистике, приблизительно половина всех разновидностей золотого микроба генерируют в процессе жизнедеятельности токсическое вещество под названием энтеротоксин. В результате у пациентов начинается рвота, сильнейшая диарея, болезненные ощущения в области брюшины.
Золотистый стафилококк — это бактерия, которая может вызывать различные инфекции у взрослых. Люди часто обсуждают, что основными причинами заражения являются несоблюдение гигиенических норм, травмы кожи и ослабленный иммунитет. Симптомы могут варьироваться от легких кожных высыпаний до серьезных заболеваний, таких как пневмония или сепсис. Многие отмечают, что при первых признаках инфекции, таких как покраснение, отек или гнойные выделения, важно немедленно обратиться к врачу. Лечение обычно включает антибиотики, однако некоторые штаммы бактерий могут быть устойчивыми к ним, что усложняет терапию. Поэтому профилактика, включая регулярное мытье рук и заботу о здоровье, играет ключевую роль в предотвращении заражения.
https://youtube.com/watch?v=HIOP4IOkqO4
Причины

В человеческий организм стафилококк проникает через любые повреждения на кожных покровах, а также вместе с инфицированной пищей. Степень тяжести поражения будет напрямую зависеть как от штамма бактерии, так и от состояния иммунитета. Чем выше будут у организма защитные функции, тем меньше шансов будет у условно-патогенного микроорганизма достичь своих целей.
Источником распространения этого микроба может являться человек, являющийся бессимптомным носителем. Также бактерия часто выявляется в молочных и мясных продуктах, в консервах и т. д.
Поспособствовать развитию в человеческом организме стафилококковой инфекции могут следующие факторы:
Признаки золотистого стафилококка

Этот грамположительный микроб способен поражать любые ткани организма. После его активизации у человека начинают развиваться инфекционно-гнойные недуги.
У взрослой аудитории больных может стафилококковая инфекция осложняться:
В группу риска подвергнуться стафилококковому инфицированию входят следующие категории людей:
- Сотрудники лечебно-профилактических учреждений.
- Будущие мамочки.
- Пожилые люди.
- Работники заведений общественного питания.
- Взрослые и дети, которые имеют ослабленный иммунитет.
- Люди, которым были диагностированы такие недуги как экзема, диабет, ревматизм, злокачественные новообразования.

Инфекция распространяется между людьми следующими способами:
Симптоматика
Если произошло инфицирование золотистым стафилококком, то у взрослых больных симптомы могут быть разнообразными.
Современной медицине известны следующие симптомы золотистого стафилококка:
Диагностические мероприятия
Прежде чем начать лечить золотистый стафилококк у детей и у взрослых специалисты проводят диагностику, цель которой заключается в дифференцировании типа возбудителя и в выявлении его мест локализации:
Методы лечения
В том случае, когда произошла генерализация инфекционного процесса, то пациентам показано лечение в условиях больничных учреждений.
Также госпитализация пациентов проводится при наличии таких осложнения:
При проведении лечения такой категории больных специалисты применяют следующие методики:

Для нормализации обменных процессов пациентам прописываются специальные лекарства, например, таблетки «Кордицепса», «Хитозана». Также прописываются витаминно-минеральные комплексы.
Больным назначаются лекарства от стафилококка золотистого из следующих групп антибиотиков:
При проведении антибактериальной терапии пациенты должны в точности соблюдать назначенную специалистами дозировку и кратность приема препаратов. Если у них практически сразу исчезает неприятная симптоматика, то им нельзя прекращать антибиотикотерапию.
При хирургическом лечении специалисты вскрывают гнойники и обеспечивают очагам беспрепятственный отток воспалительно-гнойного экссудата. Далее осуществляется их промывание антисептическими растворами, и устанавливаются дренажи. Для ускорения процесса очистки гнойных ран задействуются ферментосодержащие лекарства-протеазы.
Очень часто в борьбе со стафилококковой инфекцией применяются бактериофаги. Такие медикаменты содержат в составе вирусы, которые поглощают патогенные микроорганизмы. При наружном проявлении инфекции применяются мази и крема, которые содержат в составе антибактериальные элементы. При гнойниковых поражениях задействуются лекарственные средства для наружной обработки кожных покровов имеющие жирную консистенцию, например, мазь «Вишневского».

Пациентам категорически запрещается искусственным образом ускорять процесс созревания гнойников. Усугубить состояние и спровоцировать осложнения могут горячие ванны, посещение саун и бань, прогревания очагов поражения. Также запрещается их вскрывать в домашних условиях, так как в рану может проникнуть инфекция и ситуация усугубится.
Для поднятия защитных сил организма пациентам прописываются препараты, имеющие растительное происхождение. Например, женьшеневую настойку, таблетки, содержащие эхинацею. Чтобы предотвратить вероятность развития рецидива, больные должны принимать витаминно-минеральные комплексы.
Параллельно люди могут задействовать народные рецепты, но только после получения врачебной консультации и отсутствии любых противопоказаний:
Последствия
Опасность стафилококковой инфекции заключается в том, что она способна спровоцировать широкий спектр осложнений.
Этот список можно пополнить:
Профилактические мероприятия

Так как вылечить золотистый стафилококк крайне сложно, по причине его невероятной устойчивости к антибактериальным препаратам, люди должны регулярно проводить профилактику инфицирования.
Им достаточно выполнять следующие рекомендации специалистов:
https://youtube.com/watch?v=1MN3a4McJhg
Вопрос-ответ
Откуда берется золотистый стафилококк у взрослых?
Причины появления золотистого стафилококка. Заразиться можно через загрязненные предметы, нестерильные медицинские инструменты, при употреблении некачественных продуктов питания или воздушно-капельным путем. Любопытно, что бактерия может долго жить на коже и не вызывать неприятных симптомов.
Что хорошо помогает от золотистого стафилококка?
Для лечения стафилококковой инфекции применяют антибиотики нового поколения — полусинтетические пенициллины, аминогликозиды и некоторые другие. Также используют бактериофаги — специфические вирусы, которые прицельно уничтожают именно стафилококки.
Советы
СОВЕТ №1
Регулярно мойте руки с мылом, особенно после посещения общественных мест и перед едой. Это поможет снизить риск заражения золотистым стафилококком, который может передаваться через контакт с зараженными поверхностями или людьми.
СОВЕТ №2
Избегайте использования общих предметов личной гигиены, таких как полотенца, бритвы и косметические принадлежности. Это поможет предотвратить распространение бактерий и снизит вероятность заражения.
СОВЕТ №3
Следите за состоянием своей кожи и немедленно обращайтесь к врачу при появлении подозрительных высыпаний или ран. Раннее выявление и лечение инфекций могут предотвратить их дальнейшее распространение и осложнения.
СОВЕТ №4
Укрепляйте иммунную систему, правильно питаясь, занимаясь физической активностью и избегая стрессов. Сильный иммунитет поможет организму бороться с инфекциями, включая золотистый стафилококк.

